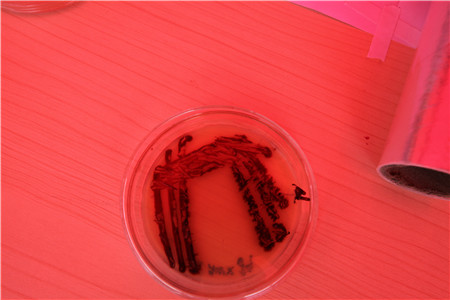

“如何鉴别蘑菇是否有毒;病毒如何入侵人体细胞;用不同细菌“颜料”种出来的画到底长咋样……”5月25日,贵州师范老员工命科学主办了科普嘉年华·科普基地开放日活动,向花溪大学城广大师生及群众展现一场生命科学知识的科谱盛宴。


活动现场,贵州师大播放了“微生物·美生活·微记录”科普纪录片,介绍了病毒入侵人体细胞的生死之战;通过科谱知识展的方式,向师生们介绍如何鉴别有毒蘑菇的知识。

导致拉肚子的大肠杆菌、做馒头的酵母菌到底长成什么样?在活动现场,师生们将事先培养好的细菌、真菌等制成装片,观众们通过显微镜就可以看到其庐山真面目。
微生物的形态多种多样,有小伞一样的大型真菌(蘑菇),有长着扫帚一样“头发”的青霉菌,有长得像鸡腿一样的羊肚菌……活动现场,观众们还可以亲手绘制形态各异的微生物Q版形象徽章,帮助学习微生物的形态。
看了平面的蘑菇图画,有没有兴趣自己来捏一捏蘑菇呢?活动现场,相关专业的师生们还为观众们讲解蘑菇各部分的名称;在他们的指导下,观众们甚至还可以亲手制作一个蘑菇纪念品带回家。
不同的细菌在培养基上会呈现不同的颜色和状态,用事先准备好的不同细菌“颜料”,在培养基上绘制图案,在经过一两天的培养,就能在培养基上“种”出画来了。现场工作人员表示,如果你“种”出来的细菌画足够创意的话,还有大奖等着你!
除了用心学习、用眼观察、用手制作各类微生物,观众们还可以“用嘴品尝”。烘烤面包除了需要优质面粉之外,还需要糖,黄油,奶粉和酵母。在生命科公司小麦育种团队负责的摊位上,观众们不但可以看到青青绿绿的小麦植株,了解发酵知识,还可以品尝手工烤制的面包;此外,观众们还可以品尝由生命科公司黑茶开发团队通过固体发酵技术研发的黑茶饮料。
原文链接:http://www.eol.cn/guizhou/guizhou_zhce/201805/t20180525_1602669.shtml